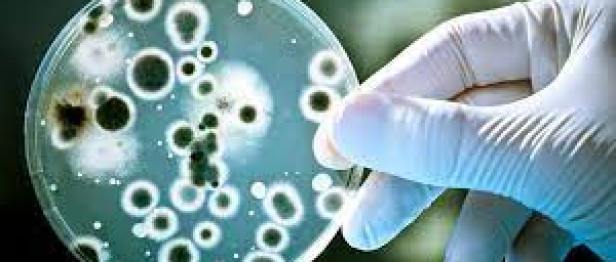

El cambio climático está aumentando la gravedad de los hongos que destruyen los cultivos, lo que crea una catástrofe mundial para la salud si no se hace nada al respecto.
Por el calentamiento global, los hongos amenazan el suministro mundial de alimentos
En un informe sorprendente, los científicos anunciaron que la esperada escasez de alimentos a gran escala volverá a causar estragos en la población mundial a menos que se controlen las infecciones fúngicas. La catástrofe de salud global que se avecina continúa amenazando a medida que las modificaciones ambientales no logran detener la rápida prevalencia del crecimiento de moho en las tierras agrícolas.
Los hongos existen en el medio ambiente y siempre han sido un problema para los agricultores. Recientemente, problemas más sofisticados como el cambio climático han aumentado su alcance y su adaptabilidad a los plaguicidas. Cabe señalar que muchos de estos hongos también son resistentes a ciertos fungicidas.

El calentamiento global favorece a los hongos
El cambio climático está ocurriendo a un ritmo más rápido de lo esperado y muchas enfermedades fúngicas están siguiendo su ejemplo. Los hallazgos iniciales indican que esto podría empeorar las consecuencias de tales infecciones en el futuro. En las últimas décadas, los patógenos fúngicos han migrado a niveles más altos de latitud a un ritmo de unos 7 km por año. Las infecciones por roya del tallo del trigo, que normalmente se encuentran en las plantas tropicales, se han confirmado en Inglaterra e Irlanda.
Pueden surgir nuevos patógenos fúngicos en condiciones climáticas más extremas, que a menudo son alimentadas por temperaturas más altas, como el aumento de las olas de calor que dominaron recientemente las noticias.
La profesora Sarah Gurr, de la Universidad de Exeter en el Reino Unido, pasó a discutir un informe reciente que analiza cómo los hongos comenzaron a llamar la atención del público a través del exitoso programa The Last of Us. Por ejemplo, el moho puede infectar su cerebro y causar serios problemas de salud.
Los científicos han advertido que podríamos ver una catástrofe de salud global debido a la rápida propagación mundial de infecciones fúngicas. Una amenaza no sobre zombis sino sobre la posible aparición de una hambruna masiva.
Crece la preocupación de que los hongos puedan sobrevivir al calentamiento global e infectar a animales y personas de sangre caliente. También existe el riesgo de más infecciones fúngicas en esas poblaciones.
La profesora Eva Stukenbrock, de la Universidad de Kiel en Alemania, coautora de «Toma de decisiones en condiciones de incertidumbre», dice: «A medida que se prevé que aumente nuestra población mundial, la humanidad enfrenta desafíos sin precedentes para la producción de alimentos». Los agricultores ya están perdiendo cultivos y viendo un aumento en el daño de los cultivos por infecciones fúngicas en todo el mundo.

Los riesgos de trágicas pérdidas de vidas
La advertencia, emitida en un artículo de la revista científica Nature , decía que los productores ya perdieron entre el 10% y el 23% de sus cultivos por enfermedades fúngicas. Los hongos son una de las muchas amenazas para los cultivos agrícolas. Impactan estas plantas de manera importante, causando pérdidas por valor de cientos de millones de dólares cada año. Sin embargo, estos organismos también ocuparon el sexto lugar en una lista reciente de las plagas y patógenos más dañinos con los mayores impactos por un factor de 10.
Los investigadores argumentan que las buenas cualidades de los hongos los hacen increíblemente resistentes. Siguen siendo viables hasta por 40 años y pueden viajar entre continentes usando sus esporas en el aire.. “Después de los tornados en Estados Unidos, se puede ver que las esporas han sido absorbidas y se han ido en viajes de larga distancia”, dijo Gurr.
El uso de fungicidas se está generalizando, pero solo ralentizan a los microbios durante un corto período de tiempo. Se sabe que las bacterias y los hongos desarrollan resistencia a los tratamientos muy rápidamente. En lugar de continuar con los métodos existentes, se ha incrementado el enfoque en la producción de nuevas tecnologías centradas en procesos celulares únicos, dicen los investigadores.
Las plantas que contienen múltiples tipos de genes para la resistencia a la infección por hongos son más sostenibles y una mejor opción para la producción de cultivos. Dinamarca hace muchas cosas por estar entre los primeros, incluido haber sido el primer país en erradicar la polio. Ahora, se está convirtiendo en la primera nación en usar drones e IA para cultivar trigo. No pasará mucho tiempo hasta que otros países también comiencen a cultivar granos de esa manera.
Pocos fondos para la investigación
Los pesticidas orgánicos se han desarrollado en el pasado, pero hay un descubrimiento reciente que condujo a compuestos que cambian la forma en que actúan los hongos. Esto haría más difícil que se vuelvan resistentes a estos pesticidas. Los investigadores ya han descubierto que el enfoque es muy efectivo contra ciertos hongos. Este descubrimiento ha contribuido a nuestra comprensión de cómo gestionar mejor todos los tipos de hongos que afectan a los cultivos.
Los investigadores criticaron la financiación de la investigación por parte del Reino Unido, diciendo que se asignó menos dinero para probar este patógeno en comparación con otras enfermedades y padecimientos.
“Si no tenemos suficiente para comer, la desnutrición nos matará antes de que tengamos algo como el covid-19”, dijo Gurr. “Pero nuestra [área de investigación] es absolutamente pobre en comparación con todas las enfermedades médicas que puedas imaginar”.
*TG/ by Damian Carrington
**EP